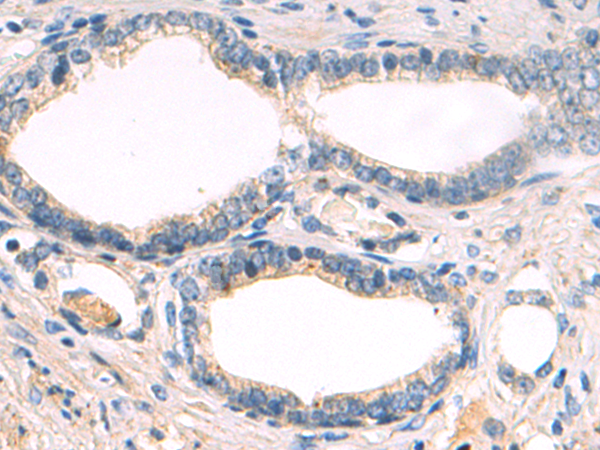

别名:MNK2; GPRK7应用:IHC
反应种属:Human, Mouse, Rat
规格:50μl/100μl
| Description |
|---|
| This gene encodes a member of the calcium/calmodulin-dependent protein kinases (CAMK) Ser/Thr protein kinase family, which belongs to the protein kinase superfamily. This protein contains conserved DLG (asp-leu-gly) and ENIL (glu-asn-ile-leu) motifs, and an N-terminal polybasic region which binds importin A and the translation factor scaffold protein eukaryotic initiation factor 4G (eIF4G). This protein is one of the downstream kinases activated by mitogen-activated protein (MAP) kinases. It phosphorylates the eukaryotic initiation factor 4E (eIF4E), thus playing important roles in the initiation of mRNA translation, oncogenic transformation and malignant cell proliferation. In addition to eIF4E, this protein also interacts with von Hippel-Lindau tumor suppressor (VHL), ring-box 1 (Rbx1) and Cullin2 (Cul2), which are all components of the CBC(VHL) ubiquitin ligase E3 complex. Multiple alternatively spliced transcript variants have been found, but the full-length nature and biological activity of only two variants are determined. These two variants encode distinct isoforms which differ in activity and regulation, and in subcellular localization. |
| Specification | |
|---|---|
| Aliases | MNK2; GPRK7 |
| Swissprot | Q9HBH9 |
| Host/Isotype | Rabbit IgG |
| Storage | Store at 4°C short term. Aliquot and store at -20°C long term. Avoid freeze/thaw cycles. |
| Species Reactivity | Human, Mouse, Rat |
| Immunogen | Fusion protein of human MKNK2 |
| Formulation | pH7.4 PBS, 0.05% NaN3, 40% Glycerol |
| Application | |
|---|---|
| IHC | 1/50-1/200 |
| ELISA | 1/5000-1/10000 |
 |
The image is immunohistochemistry of paraffin-embedded Human liver cancer tissue using P03008(MKNK2 Antibody) at dilution 1/70. (Original magnification: ×200) |
|
The image is immunohistochemistry of paraffin-embedded Human prostate cancer tissue using P03008(MKNK2 Antibody) at dilution 1/70. (Original magnification: ×200) |
本公司的所有产品仅用于科学研究或者工业应用等非医疗目的,不可用于人类或动物的临床诊断或治疗,非药用,非食用。
暂无评论
本公司的所有产品仅用于科学研究或者工业应用等非医疗目的,不可用于人类或动物的临床诊断或治疗,非药用,非食用。
 中文
中文 








发表回复